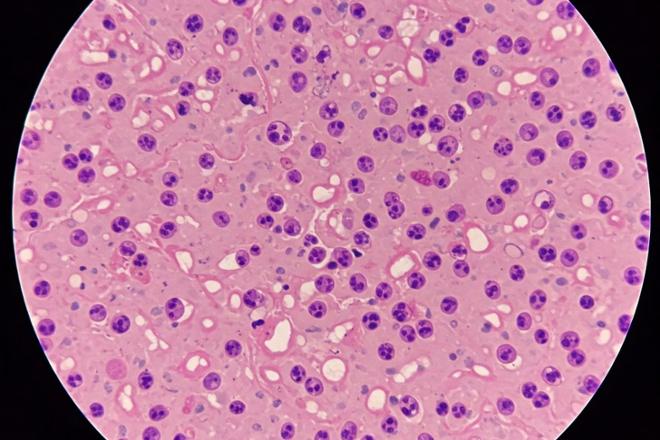
¿La citología duele?

- Sanitas
- Biblioteca de Salud
- Ginecologia
- Exploraciones ginecológicas
- Particulares y autónomos
- Empresas
-
Contacto telefónicoResuelve tus dudasL-V de 8:00h a 22:00h S de 10-14h y 16-20h917210587Si quieres contratar un seguro te llamamos gratisL-V de 9:00h a 21:00h
- 91 721 05 87
- Abrir buscador Abrir buscador
-
Mi Sanitas
Mi Sanitas
Acceder a Mi SanitasAcceder a Mi Sanitas
Gestiona tus citas, haz videoconsulta, consulta tu historial médico, solicita un reembolso…. desde Mi Sanitas podrás gestionar todo lo relacionado con tu salud y la de los tuyos.